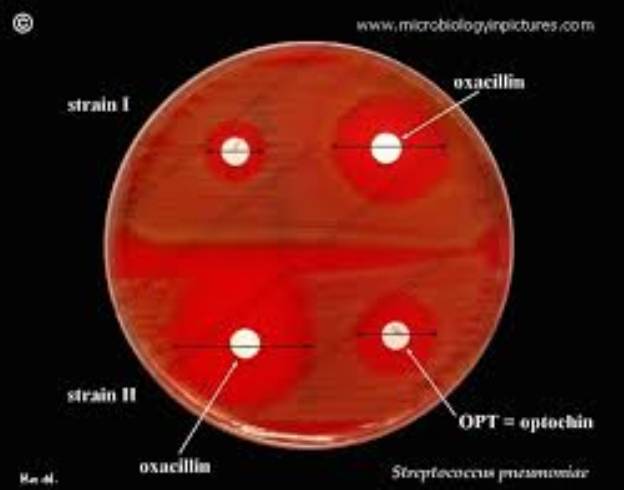

Cùng với sự phát triển kháng thuốc của nhiều tác nhân vi khuẩn, virus, nấm và ký sinh trùng hiện nay đang diễn ra trên phạm vi toàn cầu và ngay tại Việt Nam. Trong đó, đáng chú ý đến các chủng phế cầu Strptococcus pneumoniae với nhiều loại kháng sinh khác nhau, ngay cả thuốc kháng sinh phổ rộng có thể do nhiều nuyên do khác nhau từ việc sử dụng thuốc không đúng mục đích, sử dụng thuốc tràn lan và quá rộng rãi tại các cơ sở điều trị và kê đơn thuốc không hợp lý cũng như sử dụng thuốc tại cộng đồng trong nhiều năm qua.
Trước tình trạng đó, việc nghiên cứu đánh giá dịch tễ học kháng thuốc, nghiên cứu thuốc mới hoặc phối hợp thuốc chống kháng và chế tạo vaccine để phòng bệnh cho phế cầu hiện đang là hướng đi của nhiều quốc gia trên thế giới cũng như tại Việt Nam. Nhân đây, chúng tôi xin chia sẻ thông tin một số nghiên cứu liên quan đến các vấn đề sức khỏe nói trên như cập nhật thông tin thế giới và cho thấy trong nghiên cứu vẫn còn nhiều điều thú vị và còn nhiều khoảng trống để chúng ta cần phải nghiên cứu và lấp lỗ hỗng này.
Antimicrobial Resistance and Respiratory Infections.
Guitor AK, Wright GD.Chest. 2018 Jun 28. pii: S0012-3692(18)30966-8. doi: 10.1016/j.chest.2018.06.019. [Epub ahead of print] Review.PMID: 29959904 Similar articles Select item 30081902115.
Resistance decay in individuals after antibiotic exposure in primary care: a systematic review and meta-analysis.
Bakhit M, Hoffmann T, Scott AM, Beller E, Rathbone J, Del Mar C.BMC Med. 2018 Aug 7;16(1):126. doi: 10.1186/s12916-018-1109-4.PMID: 30081902 Free PMC Article Similar articles Select item 19940002116.

Hình 1
What is the mechanism for persistent coexistence of drug-susceptible and drug-resistant strains of Streptococcus pneumoniae?Colijn C, Cohen T, Fraser C, Hanage W, Goldstein E, Givon-Lavi N, Dagan R, Lipsitch M.J R Soc Interface. 2010 Jun 6;7(47):905-19. doi: 10.1098/rsif.2009.0400. Epub 2009 Nov 25.PMID: 19940002 Free PMC Article Similar articles Select item 30077545117.
Infection and metabolism - Streptococcus pneumoniae metabolism facing the host environment.Leonard A, Lalk M.Cytokine. 2018 Aug 1. pii: S1043-4666(18)30319-3. doi: 10.1016/j.cyto.2018.07.021. [Epub ahead of print]PMID: 30077545 Similar articles Select item 29263066118.
Prediction of Fluoroquinolone Susceptibility Directly from Whole-Genome Sequence Data by Using Liquid Chromatography-Tandem Mass Spectrometry To Identify Mutant Genotypes.Wan Nur Ismah WAK, Takebayashi Y, Findlay J, Heesom KJ, Jiménez-Castellanos JC, Zhang J, Graham L, Bowker K, Williams OM, MacGowan AP, Avison MB.Antimicrob Agents Chemother. 2018 Feb 23;62(3). pii: e01814-17. doi: 10.1128/AAC.01814-17. Print 2018 Mar.PMID: 29263066 Free PMC ArticleSimilar articlesSelect item 29992898119.
Antimicrobial Resistance among Staphylococci of Animal Origin.Schwarz S, Feßler AT, Loncaric I, Wu C, Kadlec K, Wang Y, Shen J.Microbiol Spectr. 2018 Jul;6(4). doi: 10.1128/microbiolspec.ARBA-0010-2017.PMID: 29992898 Similar articlesSelect item 29925579120.
The evolution of antibiotic resistance in a structured host population.Blanquart F, Lehtinen S, Lipsitch M, Fraser C.J R Soc Interface. 2018 Jun;15(143). pii: 20180040. doi: 10.1098/rsif.2018.0040.PMID: 29925579 Free PMC Article Similar articles
Deciphering the distance to antibiotic resistance for the pneumococcus using genome sequencing data.Mobegi FM, Cremers AJ, de Jonge MI, Bentley SD, van Hijum SA, Zomer A.Sci Rep. 2017 Feb 16;7:42808. doi: 10.1038/srep42808.PMID: 28205635 Free PMC ArticleSimilar articles
Antibiotic resistance of Streptococcus pneumoniae, isolated from nasopharynx of preschool children with acute respiratory tract infection in Lithuania.Stacevičienė I, Petraitienė S, Vaičiūnienė D, Alasevičius T, Kirslienė J, Usonis V.BMC Infect Dis. 2016 May 20;16:216. doi: 10.1186/s12879-016-1544-9.PMID: 27206423 Free PMC Article Similar articles Select item 238493142.

Hình 2
Nasopharyngeal carriage, serotype distribution and antimicrobial resistance of Streptococcus pneumoniae among children from Brazil before the introduction of the 10-valent conjugate vaccine.Neves FP, Pinto TC, Corrêa MA, dos Anjos Barreto R, de Souza Gouveia Moreira L, Rodrigues HG, Cardoso CA, Barros RR, Teixeira LM.BMC Infect Dis. 2013 Jul 13;13:318. doi: 10.1186/1471-2334-13-318.PMID: 23849314 Free PMC Article Similar articles Select item 94477793.
Nasopharyngeal carriage of community-acquired, antibiotic-resistant Streptococcus pneumoniae in a Zambian paediatric population.Woolfson A, Huebner R, Wasas A, Chola S, Godfrey-Faussett P, Klugman K.Bull World Health Organ. 1997;75(5):453-62.PMID: 9447779 Free PMC Article Similar articles Select item 280568284.
Pneumococcal carriage and antibiotic susceptibility patterns from two cross-sectional colonization surveys among children aged <5 years prior to the introduction of 10-valent pneumococcal conjugate vaccine - Kenya, 2009-2010.Kobayashi M, Conklin LM, Bigogo G, Jagero G, Hampton L, Fleming-Dutra KE, Junghae M, Carvalho MD, Pimenta F, Beall B, Taylor T, Laserson KF, Vulule J, Van Beneden C, Kim L, Feikin DR, Whitney CG, Breiman RF.BMC Infect Dis. 2017 Jan 5;17(1):25. doi: 10.1186/s12879-016-2103-0.PMID: 28056828 Free PMC Article Similar articles Select item 145231785.
Antibiotic-resistant Streptococcus pneumoniae in the heptavalent pneumococcal conjugate vaccine era: predictors of carriage in a multicommunity sample.Finkelstein JA, Huang SS, Daniel J, Rifas-Shiman SL, Kleinman K, Goldmann D, Pelton SI, DeMaria A, Platt R.Pediatrics. 2003 Oct;112(4):862-9.PMID: 14523178 Free Article Similar articles Select item 287763376.

Hình 3
Changes in the Serotype Distribution among Antibiotic Resistant Carriage Streptococcus pneumoniae Isolates in Children after the Introduction of the Extended-Valency Pneumococcal Conjugate Vaccine.Lee JK, Yun KW, Choi EH, Kim SJ, Lee SY, Lee HJ.J Korean Med Sci. 2017 Sep;32(9):1431-1439. doi: 10.3346/jkms.2017.32.9.1431.PMID: 28776337 Free PMC Article Similar articles Select item 105751517.
Nasopharyngeal carriage of multidrug-resistant Streptococcus pneumoniae in institutionalized HIV-infected and HIV-negative children in northeastern Romania.Leibovitz E, Dragomir C, Sfartz S, Porat N, Yagupsky P, Jica S, Florescu L, Dagan R.Int J Infect Dis. 1999 Summer;3(4):211-5.PMID: 10575151 Free Article Similar articles Select item 258603948.
Streptococcus pneumoniae nasopharyngeal colonisation in children aged under six years with acute respiratory tract infection in Lithuania, February 2012 to March 2013.Usonis V, Stacevičienė I, Petraitienė S, Vaičiūnienė D, Alasevičius T, Kirslienė J.Euro Surveill. 2015 Apr 2;20(13):34-41.PMID: 25860394 Free Article Similar articles Select item 254612439.
Nasopharyngeal carriage of Streptococcus pneumoniae in Romanian children before the introduction of the pneumococcal conjugated vaccination into the national immunization programme: a national, multi-centre, cross-sectional observational study.Luminos M, Dorobat O, Jugulete G, Popescu GA, Florea D, Draganescu A, Cercel AS, Rafila A; SP5000 study group.Int J Infect Dis. 2014 Dec;29:169-73. doi: 10.1016/j.ijid.2014.08.020. Epub 2014 Oct 30.PMID: 25461243 Free Article Similar articles Select item 2332864410.
High prevalence of Streptococcus pneumoniae in adenoids and nasopharynx in preschool children with recurrent upper respiratory tract infections in Poland--distribution of serotypes and drug resistance patterns.Niedzielski A, Korona-Glowniak I, Malm A.Med Sci Monit. 2013 Jan 18;19:54-60.PMID: 23328644 Free PMC Article Similar articlesSelect item 2770624711.
Nasopharyngeal Pneumococcal Carriage among Healthy Children in Cyprus Post Widespread Simultaneous Implementation of PCV10 and PCV13 Vaccines.Hadjipanayis A, Efstathiou E, Alexandrou M, Panayiotou L, Zachariadou C, Petrou P, Papaevangelou V.PLoS one. 2016 Oct 5;11(10):e0163269. doi: 10.1371/journal.pone.0163269. eCollection 2016.PMID: 27706247 Free PMC Article Similar articles Select item 1754241312.
Antimicrobial resistance and serotypes of nasopharyngeal strains of Streptococcus pneumoniae in Chinese children with acute respiratory infections.Yao K, Shen X, Yul S, Lu Q, Deng L, Ye Q, Zhang H, Deng Q, Hu Y, Yang Y.J Int Med Res. 2007 Mar-Apr;35(2):253-67.PMID: 17542413 Similar articlesSelect item 1158143613.
High rates of multiple antibiotic resistance in Streptococcus pneumoniae from healthy children living in isolated rural communities: association with cephalosporin use and intrafamilial transmission.Samore MH, Magill MK, Alder SC, Severina E, Morrison-De Boer L, Lyon JL, Carroll K, Leary J, Stone MB, Bradford D, Reading J, Tomasz A, Sande MA.Pediatrics. 2001 Oct;108(4):856-65.PMID: 11581436 Similar articles Select item 942858414.

Hình 4
Streptococcus pneumoniae: low frequency of penicillin resistance and high resistance to trimethoprim-sulfamethoxazole in nasopharyngeal isolates from children in a rural area in Mexico.Miranda Novales MG, Solorzano Santos F, Guiscafre Gallardo H, Leaños Miranda B, Echaniz Aviles G, Carnalla Barajas MN, Palafox Torres M, Muñoz Hernandez O.Arch Med Res. 1997 Winter;28(4):559-63.PMID: 9428584 Similar articlesSelect item 2446293015.
Serotypes and antibiotic resistance of non-invasive Streptococcus pneumoniae circulating in pediatric hospitals in Moscow, Russia.Mayanskiy N, Alyabieva N, Ponomarenko O, Lazareva A, Katosova L, Ivanenko A, Kulichenko T, Namazova-Baranova L, Baranov A.Int J Infect Dis. 2014 Mar;20:58-62. doi: 10.1016/j.ijid.2013.11.005. Epub 2014 Jan 21.PMID: 24462930 Free Article Similar articles Select item 2162157816.
Nasopharyngeal carriage of Streptococcus pneumoniae in Taiwan before and after the introduction of a conjugate vaccine.Kuo CY, Hwang KP, Hsieh YC, Cheng CH, Huang FL, Shen YH, Huang YC, Chiu CH, Chen PY, Lin TY.Vaccine. 2011 Jul 18;29(32):5171-7. doi: 10.1016/j.vaccine.2011.05.034. Epub 2011 May 27.PMID: 21621578 Similar articlesSelect item 1872780417.
Antibiotic susceptibility and molecular epidemiology of nasopharyngeal pneumococci from Spanish children.Sánchez-Tatay D, Arroyo LA, Tarragó D, Lirola MJ, Porras A, Fenoll A, Hausdorff WP, Brueggemann AB, Obando I.Clin Microbiol Infect. 2008 Aug;14(8):797-801. doi: 10.1111/j.1469-0691.2008.02025.x.PMID: 18727804 Free Article Similar articles Select item 1869742018.
[Nasopharyngeal carriage of Streptococcus pneumoniae in healthy children and multidrug resistance].Bayer M, Aslan G, Emekdaş G, Kuyucu N, Kanik A.Mikrobiyol Bul. 2008 Apr;42(2):223-30. Turkish. PMID: 18697420 Similar articlesSelect item 1535541019.
A cross-sectional survey of the prevalence of Streptococcus pneumoniae nasopharyngeal carriage in Belgian infants attending day care centres.Malfroot A, Verhaegen J, Dubru JM, Van Kerschaver E, Leyman S.Clin Microbiol Infect. 2004 Sep;10(9):797-803.PMID: 15355410 Free Article Similar articlesSelect item 1554585620.
Seven valent pneumococcal conjugate vaccine immunization in two Boston communities: changes in serotypes and antimicrobial susceptibility among Streptococcus pneumoniae isolates.Pelton SI, Loughlin AM, Marchant CD.Pediatr Infect Dis J. 2004 Nov;23(11):1015-22.PMID: 15545856 Similar articles
Effect of a nonavalent conjugate vaccine on carriage of antibiotic-resistant Streptococcus pneumoniae in day-care centers.Dagan R, Givon-Lavi N, Zamir O, Fraser D.Pediatr Infect Dis J. 2003 Jun;22(6):532-40.PMID: 12799510 Similar articlesSelect item 2754687522.
Emergence of antibiotic-resistant non-vaccine serotype pneumococci in nasopharyngeal carriage in children after the use of extended-valency pneumococcal conjugate vaccines in Korea.Choe YJ, Lee HJ, Lee H, Oh CE, Cho EY, Choi JH, Kang HM, Yoon IA, Jung HJ, Choi EH.Vaccine. 2016 Sep 14;34(40):4771-6. doi: 10.1016/j.vaccine.2016.08.030. Epub 2016 Aug 18.PMID: 27546875 Similar articles Select item 2535594023.
Efficacy of 13-valent pneumococcal conjugate vaccine (PCV13) versus that of 7-valent PCV (PCV7) against nasopharyngeal colonization of antibiotic-nonsusceptible Streptococcus pneumoniae.Dagan R, Juergens C, Trammel J, Patterson S, Greenberg D, Givon-Lavi N, Porat N, Gurtman A, Gruber WC, Scott DA.J Infect Dis. 2015 Apr 1;211(7):1144-53. doi: 10.1093/infdis/jiu576. Epub 2014 Oct 29.PMID: 25355940 Similar articles Select item 2434224924.
Serotype distribution and antimicrobial susceptibilities of nasopharyngeal isolates of Streptococcus pneumoniae from healthy children in the 13-valent pneumococcal conjugate vaccine era.Zuccotti G, Mameli C, Daprai L, Garlaschi ML, Dilillo D, Bedogni G, Faccini M, Gramegna M, Torresani E; PneuMi Study Group (PMSG), Ballerini E, Benincaso A, Bonvissuto M, Bricalli D, Brioschi M, Calloni CS, Camiletti MI, Colella G, De Angelis L, Decarlis S, Di Nello F, Dozzi M, Galli E, Gandini V, Giuliani MG, Laviola F, Loda B, Macedoni M, Mazzucchi E, Metta MG, Moscatiello A, Nannini P, Petruzzi M, Picicco D, Picciotti M, Pisanelli S, Porta N, Ramponi G, Redaelli F, Rubini R, Sala N, Saitta V, Scelza G, Tiso RM, Tomasetto M, Torcoletti M, Travaini M, Valentini M, Vessia C.Vaccine. 2014 Jan 23;32(5):527-34. doi: 10.1016/j.vaccine.2013.12.003. Epub 2013 Dec 14.PMID: 24342249 Similar articles Select item 1683685625.
[Surveillance of antimicrobial susceptibility of Streptococcus pneumoniae and Hemophilus influenzae isolated from children in Guangzhou area between 2003 and 2004].Huang XQ, Xiao ZY, Deng L, Deng QL, Xie YQ, Yang YH.Zhonghua Er Ke Za Zhi. 2006 Jun;44(6):441-4. Chinese. PMID: 16836856 Similar articles Select item 2311375126.
Low rate of pneumococci non-susceptible to penicillin in healthy Swedish toddlers.Skovbjerg S, Söderström A, Hynsjö L, Normark BH, Ekdahl K, Åhrén C.Scand J Infect Dis. 2013 Apr;45(4):279-84. doi: 10.3109/00365548.2012.734919. Epub 2012 Oct 31.PMID: 23113751 Similar articles Select item 2197867027.
[Study of nasopharyngeal colonization by Streptococcus pneumoniae and its antibiotics resistance in healthy children less than 2 years of age in the Marrakech region (Morocco)].Bouskraoui M, Soraa N, Zahlane K, Arsalane L, Doit C, Mariani P, Bingen E.Arch Pediatr. 2011 Dec;18(12):1265-70. doi: 10.1016/j.arcped.2011.08.028. Epub 2011 Oct 5. French. PMID: 21978670 Similar articles Select item 1745489128.
Antibiotic susceptibility, serotype distribution and vaccine coverage of nasopharyngeal and oropharyngeal Streptococcus pneumoniae in a day-care centre in St. Petersburg, Russia.Katz A, Leibovitz E, Timchenko VN, Greenberg D, Porat N, Peled N, Dagan R, Ossipov IB.Scand J Infect Dis. 2007;39(4):293-8.PMID: 17454891 Similar articles Select item 2244229229.

Hình 5
Penicillin resistance and serotype distribution of Streptococcus pneumoniae in nasopharyngeal carrier children under 5 years of age in Dar es Salaam, Tanzania.Moyo SJ, Steinbakk M, Aboud S, Mkopi N, Kasubi M, Blomberg B, Manji K, Lyamuya EF, Maselle SY, Langeland N.J Med Microbiol. 2012 Jul;61(Pt 7):952-9. doi: 10.1099/jmm.0.042598-0. Epub 2012 Mar 22.PMID: 22442292 Similar articlesSelect item 2423743730.
[Serotype distribution and antibiotic susceptibilities of Streptococcus pneumoniae causing acute exacerbations and pneumonia in children with chronic respiratory diseases].Altınkanat Gelmez G, Soysal A, Kuzdan C, Karadağ B, Hasdemir U, Bakır M, Söyletir G.Mikrobiyol Bul. 2013 Oct;47(4):684-92. Turkish. PMID: 24237437 Free Article Similar articles Select item 2708076631.
Genotyping and serotyping of macrolide and multidrug resistant Streptococcus pneumoniae isolated from carrier children.Swedan SF, Hayajneh WA, Bshara GN.Indian J Med Microbiol. 2016 Apr-Jun;34(2):159-65. doi: 10.4103/0255-0857.176840.PMID: 27080766 Free Article Similar articles Select item 2368044032.
Changes in Streptococcus pneumoniae serotype distribution in invasive disease and nasopharyngeal carriage after the heptavalent pneumococcal conjugate vaccine introduction in Bogotá, Colombia.Parra EL, De La Hoz F, Díaz PL, Sanabria O, Realpe ME, Moreno J.Vaccine. 2013 Aug 20;31(37):4033-8. doi: 10.1016/j.vaccine.2013.04.074. Epub 2013 May 14. PMID: 23680440 Similar articles Select item 2534417733.
[Nasopharyngeal carriage rate, antimicrobial resistance and serotype distribution of Streptococcus pneumoniae among children with upper respiratory infection].Yu SJ, Gao W, Shi W, Yuan L, Shen AD, Yao KH, Yang YH.Zhongguo Dang Dai Er Ke Za Zhi. 2014 Oct;16(10):988-92. Chinese. PMID: 25344177 Free Article Similar articles Select item 2292778734.
Characteristics of Streptococcus pneumoniae strains colonizing upper respiratory tract of healthy preschool children in Poland.Korona-Glowniak I, Malm A.ScientificWorldJournal. 2012;2012:732901. doi: 10.1100/2012/732901. Epub 2012 Aug 2.PMID: 22927787 Free PMC Article Similar articles Select item 1529389635.
[The epidemiology of nasopharyngeal colonisation of Streptococcus pneumoniae in children with respiratory tract infection].Ilki A, Akbenlioğlu C, Yağci A, Söyletir G, Bakir M.Mikrobiyol Bul. 2004 Jan-Apr;38(1-2):1-7. Turkish. PMID: 15293896 Similar articlesSelect item 2576171836.
Epidemiology of pneumococcal carriage in children under five years of age in Accra, Ghana.Mills RO, Twum-Danso K, Owusu-Agyei S, Donkor ES.Infect Dis (Lond). 2015 May;47(5):326-31. doi: 10.3109/00365548.2014.994185. Epub 2015 Mar 11.PMID: 25761718 Similar articles Select item 1707212137.
Impact of pneumococcal conjugate vaccine and of reduction of antibiotic use on nasopharyngeal carriage of nonsusceptible pneumococci in children with acute otitis media.Cohen R, Levy C, de La Rocque F, Gelbert N, Wollner A, Fritzell B, Bonnet E, Tetelboum R, Varon E.Pediatr Infect Dis J. 2006 Nov;25(11):1001-7.PMID: 17072121 Similar articlesSelect item 1458256138.

Hình 6
Rate of nasopharyngeal carriage, antimicrobial resistance and serotype of Streptococcus pneumoniae among children in northern Taiwan.Lo WT, Wang CC, Yu CM, Chu ML.J Microbiol Immunol Infect. 2003 Sep;36(3):175-81.PMID: 14582561 Similar articlesSelect item 1881996639.
Has the licensing of respiratory quinolones for adults and the 7-valent pneumococcal conjugate vaccine (PCV-7) for children had herd effects with respect to antimicrobial non-susceptibility in invasive Streptococcus pneumoniae?Fenoll A, Aguilar L, Granizo JJ, Giménez MJ, Aragoneses-Fenoll L, Mendez C, Tarragó D.J Antimicrob Chemother. 2008 Dec;62(6):1430-3. doi: 10.1093/jac/dkn413. Epub 2008 Sep 26. PMID: 18819966 Similar articlesSelect item 2622644540.
Decline in Pneumococcal Nasopharyngeal Carriage of Vaccine Serotypes After the Introduction of the 13-Valent Pneumococcal Conjugate Vaccine in Children in Atlanta, Georgia.Desai AP, Sharma D, Crispell EK, Baughman W, Thomas S, Tunali A, Sherwood L, Zmitrovich A, Jerris R, Satola SW, Beall B, Moore MR, Jain S, Farley MM.Pediatr Infect Dis J. 2015 Nov;34(11):1168-74. doi: 10.1097/INF.0000000000000849.PMID: 26226445 Similar articles
Pneumococcal carriage and antibiotic resistance in young children before 13-valent conjugate vaccine.Wroe PC, Lee GM, Finkelstein JA, Pelton SI, Hanage WP, Lipsitch M, Stevenson AE, Rifas-Shiman SL, Kleinman K, Dutta-Linn MM, Hinrichsen VL, Lakoma M, Huang SS.Pediatr Infect Dis J. 2012 Mar;31(3):249-54. doi: 10.1097/INF.0b013e31824214ac.PMID: 22173142 Free PMC Article Similar articles Select item 2183913542.
Serotype distribution and antibiotic resistance of 140 pneumococcal isolates from pediatric patients with upper respiratory infections in Beijing, 2010.Zhou L, Yu SJ, Gao W, Yao KH, Shen AD, Yang YH.Vaccine. 2011 Oct 13;29(44):7704-10. doi: 10.1016/j.vaccine.2011.07.137. Epub 2011 Aug 10.PMID: 21839135 Similar articles Select item 2697474943.
Bacterial Density, Serotype Distribution and Antibiotic Resistance of Pneumococcal Strains from the Nasopharynx of Peruvian Children Before and After Pneumococcal Conjugate Vaccine 7.Hanke CR, Grijalva CG, Chochua S, Pletz MW, Hornberg C, Edwards KM, Griffin MR, Verastegui H, Gil AI, Lanata CF, Klugman KP, Vidal JE.Pediatr Infect Dis J. 2016 Apr;35(4):432-9. doi: 10.1097/INF.0000000000001030.PMID: 26974749 Free PMC Article Similar articles Select item 1460826644.
Nasopharyngeal colonization of Streptococcus pneumoniae in healthy children: percentage of carriers, serotypes distribution and antibiotic resistance.Schettini F Jr, Miragliotta G, Carucci A, Mosca A, Del Vecchio GC, Laforgia N, De Mattia D.Minerva Pediatr. 2003 Oct;55(5):439-45. Italian. PMID: 14608266 Similar articles Select item 2726905945.
The impact of a pneumococcal conjugate vaccination program on the nasopharyngeal carriage, serotype distribution and antimicrobial resistance of Streptococcus pneumoniae among healthy children in Turkey.Soysal A, Karabağ-Yılmaz E, Kepenekli E, Karaaslan A, Cagan E, Atıcı S, Atınkanat-Gelmez G, Boran P, Merdan S, Hasdemir U, Söyletir G, Bakır M.Vaccine. 2016 Jul 19;34(33):3894-900. doi: 10.1016/j.vaccine.2016.05.043. Epub 2016 Jun 11.PMID: 27269059 Similar articles Select item 1803557046.

Hình 7
Increasing penicillin and trimethoprim-sulfamethoxazole resistance in nasopharyngeal Streptococcus pneumoniae isolates from Guatemalan children, 2001--2006.Dueger EL, Asturias EJ, Matheu J, Gordillo R, Torres O, Halsey N.Int J Infect Dis. 2008 May;12(3):289-97. Epub 2007 Nov 26.PMID: 18035570 Free PMC Article Similar articles Select item 1578430647.
Susceptibility patterns of Streptococcus pneumoniae isolates in North America (2002-2003): contemporary in vitro activities of amoxicillin/clavulanate and 15 other antimicrobial agents.Pottumarthy S, Fritsche TR, Sader HS, Stilwell MG, Jones RN.Int J Antimicrob Agents. 2005 Apr;25(4):282-9.PMID: 15784306 Similar articlesSelect item 2142968248.
[Nasopharyngeal carriage, antibiotic susceptibility and serotyping of Streptococcus pneumoniae and Haemophilus influenzae in children attending day care centers].Chavanet P, Atale A, Mahy S, Neuwirth C, Varon E, Dabernat H, Portier H.Med Mal Infect. 2011 Jun;41(6):307-17. doi: 10.1016/j.medmal.2011.02.001. Epub 2011 Mar 22. French. PMID: 21429682 Similar articlesSelect item 2194005649.
Upper respiratory colonization by Streptococcus pneumoniae in healthy pre-school children in south-east Poland.Korona-Glowniak I, Niedzielski A, Malm A.Int J Pediatr Otorhinolaryngol. 2011 Dec;75(12):1529-34. doi: 10.1016/j.ijporl.2011.08.021. Epub 2011 Sep 21.PMID: 21940056 Similar articles Select item 1631377050.
[Carrier rate of Streptococcus pneumoniae and susceptibility thereof to antimicrobial drugs among children in China: a surveillance study in Beijing, Shanghai, and Guangzhou 2000-2002].Yao KH, Lu Q, Deng L, Yu SJ, Zhang H, Deng QL, Shen XZ, Yang YH.Zhonghua Yi Xue Za Zhi. 2005 Jul 27;85(28):1957-61. Chinese. PMID: 16313770 Similar articles Select item 2642357151.
The influence of Streptococcus pneumoniae nasopharyngeal colonization on the clinical outcome of the respiratory tract infections in preschool children.Petraitiene S, Alasevicius T, Staceviciene I, Vaiciuniene D, Kacergius T, Usonis V.BMC Infect Dis. 2015 Sep 30;15:403. doi: 10.1186/s12879-015-1149-8.PMID: 26423571 Free PMC Article Similar articles Select item 1499009852.
[Antibiotics-resistance pattern and genetic type of Streptococcus pneumoniae isolated from children in Hangzhou].Hua CZ, Shang SQ, Sun XF, Li JP, Chen ZM, Yu XL.Zhonghua Er Ke Za Zhi. 2004 Jan;42(1):16-9. Chinese. PMID: 14990098 Similar articlesSelect item 2632401453.
Antibiotic susceptibility rates of invasive pneumococci before and after the introduction of pneumococcal conjugate vaccination in Germany.Imöhl M, Reinert RR, van der Linden M.Int J Med Microbiol. 2015 Oct;305(7):776-83. doi: 10.1016/j.ijmm.2015.08.031. Epub 2015 Aug 22.PMID: 26324014 Similar articles Select item 1994102154.
Interaction of the heptavalent pneumococcal conjugate vaccine and the use of individual antibiotics among children on nasopharyngeal colonization with erythromycin-resistant Streptococcus pneumoniae.Grivea IN, Tsantouli AG, Chryssanthopoulou DC, Syrogiannopoulos GA.Eur J Clin Microbiol Infect Dis. 2010 Jan;29(1):97-105. doi: 10.1007/s10096-009-0826-1. Epub 2009 Nov 26.PMID: 19941021 Similar articles Select item 2404621955.
Nasopharyngeal carriage of Streptococcus pneumoniae in healthy Turkish children after the addition of PCV7 to the national vaccine schedule.Ozdemir H, Ciftçi E, Durmaz R, Güriz H, Aysev AD, Karbuz A, Gökdemir R, Acar B, Nar Ötgün S, Ertek M, Köse SK, Ince E.Eur J Pediatr. 2014 Mar;173(3):313-20. doi: 10.1007/s00431-013-2156-7. Epub 2013 Sep 18.PMID: 24046219 Similar articlesSelect item 1133722756.
High prevalence of carriage of antibiotic-resistant Streptococcus pneumoniae in children in Kampala Uganda.Joloba ML, Bajaksouzian S, Palavecino E, Whalen C, Jacobs MR.Int J Antimicrob Agents. 2001 May;17(5):395-400.PMID: 11337227 Similar articlesSelect item 1119603357.
Prevalence of nasopharyngeal antibiotic-resistant pneumococcal carriage in children attending private paediatric practices in Johannesburg.Huebner RE, Wasas AD, Klugman KP; Paediatric Study Group.S Afr Med J. 2000 Nov;90(11):1116-21.PMID: 11196033 Similar articles Select item 2182132058.
Hình 8
Epidemiology of nasopharyngeal carriage of Streptococcus pneumoniae in children < 6 years old in seville.Obando I, Sánchez-Tatay D, Molinos-Quintana A, Delgado-Pecellin I, Porras A, Morillo-Gutiérrez B, Fenoll A, Lirola MJ.Enferm Infecc Microbiol Clin. 2011 Oct;29(8):581-6. doi: 10.1016/j.eimc.2011.05.010. Epub 2011 Aug 6. Spanish. PMID: 21821320 Similar articles Select item 861818859.
Colonization with antibiotic-resistant Streptococcus pneumoniae in children with sickle cell disease.Steele RW, Warrier R, Unkel PJ, Foch BJ, Howes RF, Shah S, Williams K, Moore S, Jue SJ.J Pediatr. 1996 Apr;128(4):531-5.PMID: 8618188 Similar articles Select item 2740513260.
Nasopharyngeal carriage of streptococcus pneumoniae in healthy children under five years old in Central Lombok regency, Indonesia.Hadinegoro SR, Prayitno A, Khoeri MM, Djelantik IG, Dewi NE, Indriyani SA, Muttaqin Z, Mudaliana S, Safari D.Southeast Asian J Trop Med Public Health. 2016 May;47(3):485-93.PMID: 27405132 Similar articles
Nationwide surveillance of nasopharyngeal Streptococcus pneumoniae isolates from children with respiratory infection, Switzerland, 1998-1999.Mühlemann K, Matter HC, Täuber MG, Bodmer T; Sentinel Working Group.J Infect Dis. 2003 Feb 15;187(4):589-96. Epub 2003 Jan 29.PMID: 12599075 Similar articles Select item 2434924562.
High nasopharyngeal carriage of non-vaccine serotypes in Western Australian aboriginal people following 10 years of pneumococcal conjugate vaccination.Collins DA, Hoskins A, Bowman J, Jones J, Stemberger NA, Richmond PC, Leach AJ, Lehmann D.PLoS one. 2013 Dec 3;8(12):e82280. doi: 10.1371/journal.pone.0082280. eCollection 2013.PMID: 24349245 Free PMC Article Similar articles Select item 2696929463.
High genetic diversity of Staphylococcus aureus strains colonising the nasopharynx of Gambian villagers before widespread use of pneumococcal conjugate vaccines.Ebruke C, Dione MM, Walter B, Worwui A, Adegbola RA, Roca A, Antonio M.BMC Microbiol. 2016 Mar 12;16:38. doi: 10.1186/s12866-016-0661-3.PMID: 26969294 Free PMC Article Similar articles Select item 2547121964.
Identifying an appropriate PCV for use in Senegal, recent insights concerning Streptococcus pneumoniae NP carriage and IPD in Dakar.Ba F, Seck A, Bâ M, Thiongane A, Cissé MF, Seck K, Ndour M, Boisier P, Garin B.BMC Infect Dis. 2014 Dec 4;14:627. doi: 10.1186/s12879-014-0627-8.PMID: 25471219 Free PMC Article Similar articles Select item 1075873565.
Susceptibility of Streptococcus pneumoniae isolated from the respiratory tract of hospitalized children with respiratory tract infections.Slobodnikova L, Kotulova D, Kapellerova A, Kotzigova A.Bratisl Lek Listy. 1999 Nov;100(11):587-92.PMID: 10758735 Similar articlesSelect item 933250866.
Resistance patterns of streptococcus pneumoniae from carriers attending day-care centers in southwestern Greece.Syrogiannopoulos GA, Grivea IN, Beratis NG, Spiliopoulou AE, Fasola EL, Bajaksouzian S, Appelbaum PC, Jacobs MR.Clin Infect Dis. 1997 Aug;25(2):188-94.PMID: 9332508 Similar articles Select item 1953604167.
Nasopharyngeal carriage of Streptococcus pneumoniae in Gambian children who participated in a 9-valent pneumococcal conjugate vaccine trial and in their younger siblings.Cheung YB, Zaman SM, Nsekpong ED, Van Beneden CA, Adegbola RA, Greenwood B, Cutts FT.Pediatr Infect Dis J. 2009 Nov;28(11):990-5. doi: 10.1097/INF.0b013e3181a78185.PMID: 19536041 Similar articlesSelect item 1646054668.
Serotypes of carriage and invasive isolates of Streptococcus pneumoniae in Brazilian children in the era of pneumococcal vaccines.Laval CB, de Andrade AL, Pimenta FC, de Andrade JG, de Oliveira RM, Silva SA, de Lima EC, Fabio JL, Casagrande ST, Brandileone MC.Clin Microbiol Infect. 2006 Jan;12(1):50-5.PMID: 16460546 Free Article Similar articles Select item 1834782269.
Serogroup distribution and antimicrobial resistance of nasopharyngeal isolates of Streptococcus pneumoniae among Beijing children with upper respiratory infections (2000-2005).Yu S, Yao K, Shen X, Zhang W, Liu X, Yang Y.Eur J Clin Microbiol Infect Dis. 2008 Aug;27(8):649-55. doi: 10.1007/s10096-008-0481-y. Epub 2008 Mar 18.PMID: 18347822 Similar articlesSelect item 2692047070.
The impact of private use of PCV7 in 2009 and 2010 on serotypes and antimicrobial resistance of Streptococcus pneumoniae carried by young children in Portugal: Comparison with data obtained since 1996 generating a 15-year study prior to PCV13 introduction.Nunes S, Félix S, Valente C, Simões AS, Tavares DA, Almeida ST, Paulo AC, Brito-Avô A, de Lencastre H, Sá-Leão R.Vaccine. 2016 Mar 29;34(14):1648-56. doi: 10.1016/j.vaccine.2016.02.045. Epub 2016 Feb 23.PMID: 26920470 Similar articlesSelect item 2632712271.
Prevalence of nasopharyngeal pneumococcal colonization in children and antimicrobial susceptibility profiles of carriage isolates.Zhou JY, Isaacson-Schmid M, Utterson EC, Todd EM, McFarland M, Sivapalan J, Niehoff JM, Burnham CD, Morley SC.Int J Infect Dis. 2015 Oct;39:50-52. doi: 10.1016/j.ijid.2015.08.010. Epub 2015 Sep 3.PMID: 26327122 Free PMC Article Similar articles Select item 2308029072.
Pneumococcal carriage and invasive disease in children before introduction of the 13-valent conjugate vaccine: comparison with the era before 7-valent conjugate vaccine.Sharma D, Baughman W, Holst A, Thomas S, Jackson D, da Gloria Carvalho M, Beall B, Satola S, Jerris R, Jain S, Farley MM, Nuorti JP.Pediatr Infect Dis J. 2013 Feb;32(2):e45-53. doi: 10.1097/INF.0b013e3182788fdd.PMID: 23080290 Similar articles Select item 1956342873.
Nasopharyngeal carriage of S. pneumoniae among young children in rural Nepal.Coles CL, Sherchand JB, Khatry SK, Katz J, Leclerq SC, Mullany LC, Tielsch JM.Trop Med Int Health. 2009 Sep;14(9):1025-33. doi: 10.1111/j.1365-3156.2009.02331.x. Epub 2009 Jun 28.PMID: 19563428 Free PMC Article Similar articles Select item 2200008774.
Changes in nasopharyngeal carriage and serotype distribution of antibiotic-resistant Streptococcus pneumoniae before and after the introduction of 7-valent pneumococcal conjugate vaccine in Hong Kong.Ho PL, Chiu SS, Chan MY, Ang I, Chow KH, Lau YL.Diagn Microbiol Infect Dis. 2011 Dec;71(4):327-34. doi: 10.1016/j.diagmicrobio.2011.09.006. Epub 2011 Oct 14.PMID: 22000087 Similar articlesSelect item 1552926975.
Impact of a conjugate vaccine on community-wide carriage of nonsusceptible Streptococcus pneumoniae in Alaska.Moore MR, Hyde TB, Hennessy TW, Parks DJ, Reasonover AL, Harker-Jones M, Gove J, Bruden DL, Rudolph K, Parkinson A, Butler JC, Schuchat A.J Infect Dis. 2004 Dec 1;190(11):2031-8. Epub 2004 Oct 27.PMID: 15529269 Similar articles Select item 1083481876.
Carriage of antibiotic-resistant Streptococcus pneumoniae in Greek infants and toddlers.Syrogiannopoulos GA, Grivea IN, Katopodis GD, Geslin P, Jacobs MR, Beratis NG.Eur J Clin Microbiol Infect Dis. 2000 Apr;19(4):288-93.PMID: 10834818 Similar articles Select item 1985713377.
Streptococcus pneumoniae nasopharyngeal carriage in children attending day-care centers in the central region of Portugal, in the era of 7-valent pneumococcal conjugate vaccine.Rodrigues F, Nunes S, Sá-Leão R, Gonçalves G, Lemos L, de Lencastre H.Microb Drug Resist. 2009 Dec;15(4):269-77. doi: 10.1089/mdr.2009.0043.PMID: 19857133 Similar articlesSelect item 965093978.
Extremely high prevalence of nasopharyngeal carriage of penicillin-resistant Streptococcus pneumoniae among children in Kaohsiung, Taiwan.Chiou CC, Liu YC, Huang TS, Hwang WK, Wang JH, Lin HH, Yen MY, Hsieh KS.J Clin Microbiol. 1998 Jul;36(7):1933-7.PMID: 9650939 Free PMC Article Similar articles Select item 2609367379.
Trends in antibiotic resistance of Streptococcus pneumoniae and Haemophilus influenzae isolated from nasopharyngeal flora in children with acute otitis media in France before and after 13 valent pneumococcal conjugate vaccine introduction.Angoulvant F, Cohen R, Doit C, Elbez A, Werner A, Béchet S, Bonacorsi S, Varon E, Levy C.BMC Infect Dis. 2015 Jun 21;15:236. doi: 10.1186/s12879-015-0978-9.PMID: 26093673 Free PMC Article Similar articles Select item 1195701980.
Prevalence, determinants, and molecular epidemiology of Streptococcus pneumoniae isolates colonizing the nasopharynx of healthy children in Rome.Petrosillo N, Pantosti A, Bordi E, Spanó A, Del Grosso M, Tallarida B, Ippolito G.Eur J Clin Microbiol Infect Dis. 2002 Mar;21(3):181-8. Epub 2002 Mar 16.PMID: 11957019 Similar articles
Nasopharyngeal carriage of penicillin-resistant Streptococcus pneumoniae in healthy children.Uzuner A, Ilki A, Akman M, Gündoğdu E, Erbölükbaş R, Kokaçya O, Mengüç T, Kalaça S, Söyletir G.Turk J Pediatr. 2007 Oct-Dec;49(4):370-8.PMID: 18246737 Similar articles Select item 2084446382.
Streptococcus pneumoniae nasopharyngeal colonization in children in Brasov, Central Romania: high antibiotic resistance and coverage by conjugate vaccines.Falup-Pecurariu O, Bleotu L, Zavarache C, Peled N, Anton O, Robu M, Falup-Pecurariu C, Rogozea L, Porat N, Greenberg D, Dagan R, Leibovitz E.Pediatr Infect Dis J. 2011 Jan;30(1):76-8. doi: 10.1097/INF.0b013e3181f42bb6.PMID: 20844463 Similar articles Select item 1078301883.
Predictive value of pneumococcal nasopharyngeal cultures for the assessment of nonresponsive acute otitis media in children.Eldan M, Leibovitz E, Piglansky L, Raiz S, Press J, Yagupsky P, Leiberman A, Dagan R.Pediatr Infect Dis J. 2000 Apr;19(4):298-303.PMID: 10783018 Similar articles Select item 2471010884.
Molecular characterization and antimicrobial susceptibility of Streptococcus pneumoniae isolated from children hospitalized with respiratory infections in Suzhou, China.Geng Q, Zhang T, Ding Y, Tao Y, Lin Y, Wang Y, Black S, Zhao G.PLoS one. 2014 Apr 7;9(4):e93752. doi: 10.1371/journal.pone.0093752. eCollection 2014.PMID: 24710108 Free PMC Article Similar articles Select item 2740560385.
Nasopharyngeal bacterial carriage in young children in Greenland: a population at high risk of respiratory infections.Navne JE, Børresen ML, Slotved HC, Andersson M, Melbye M, Ladefoged K, Koch A.Epidemiol Infect. 2016 Nov;144(15):3226-3236. Epub 2016 Jul 13.PMID: 27405603 Similar articles Select item 1271880786.
Serotypes of respiratory tract isolates of Streptococcus pneumoniae from Jamaican children.Allen UD, Thomas S, Carapetis J, Henry S, Wasfy S, Lovgren M, Richardson S, Low DE.Int J Infect Dis. 2003 Mar;7(1):29-35.PMID: 12718807 Free Article Similar articles Select item 1859228187.
Low incidence of antibiotic resistance among invasive and nasopharyngeal isolates of Streptococcus pneumoniae from children in rural Philippines between 1994 and 2000.Sombrero L, Nissinen A, Esparar G, Lindgren M, Siira L, Virolainen A; ARIVAC consortium.Eur J Clin Microbiol Infect Dis. 2008 Oct;27(10):929-35. doi: 10.1007/s10096-008-0524-4. Epub 2008 Jul 1.PMID: 18592281 Similar articles Select item 957638188.
The use of Streptococcus pneumoniae nasopharyngeal isolates from healthy children to predict features of invasive disease.Kellner JD, McGeer A, Cetron MS, Low DE, Butler JC, Matlow A, Talbot J, Ford-Jones EL.Pediatr Infect Dis J. 1998 Apr;17(4):279-86.PMID: 9576381 Similar articles Select item 983167189.
Nasopharyngeal carriage and antimicrobial resistance in isolates of Streptococcus pneumoniae and Haemophilus influenzae type b in children under 5 years of age in Botswana.Huebner RE, Wasas A, Mushi A, Mazhani L, Klugman K.Int J Infect Dis. 1998 Jul-Sep;3(1):18-25.PMID: 9831671 Free Article Similar articles Select item 1725987390.
Increased antimicrobial resistance among nonvaccine serotypes of Streptococcus pneumoniae in the pediatric population after the introduction of 7-valent pneumococcal vaccine in the United States.Farrell DJ, Klugman KP, Pichichero M.Pediatr Infect Dis J. 2007 Feb;26(2):123-8.PMID: 17259873 Similar articles Select item 2304337891.
Molecular characteristics of erythromycin-resistant Streptococcus pneumoniae from pediatric patients younger than five years in Beijing, 2010.Zhou L, Ma X, Gao W, Yao KH, Shen AD, Yu SJ, Yang YH.BMC Microbiol. 2012 Oct 9;12:228. doi: 10.1186/1471-2180-12-228.PMID: 23043378 Free PMC Article Similar articles Select item 1063498392.